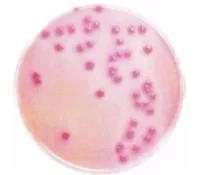
圖片

1、指一群在36℃條件下培養(yǎng)48h能發(fā)酵乳糖、產(chǎn)酸產(chǎn)氣的需氧和兼性厭氧革蘭氏陰性無芽胞桿菌。
2、該菌群主要來源于人畜糞便, 作為糞便污染指標(biāo)評(píng)價(jià)食品的衛(wèi)生狀況, 推斷食品中腸道致病菌污染的可能。
3、大腸菌群不是細(xì)菌學(xué)上分類命名,而是一組與糞便污染有關(guān)的細(xì)菌。這群細(xì)菌包括:大腸埃希氏菌、檸檬酸桿菌、產(chǎn)氣克雷伯氏菌和陰溝腸桿菌。
4、生化特征及血清學(xué)反應(yīng)并非完全一致。
5、典型大腸桿菌的IMVIC與硫化氫試驗(yàn)結(jié)果:++---。
二、分布:
1、廣泛分布于自然環(huán)境。
2、來源于人和溫血?jiǎng)游锏募S便。
三、衛(wèi)生學(xué)意義:
1、大腸菌群作為糞便污染的指標(biāo)菌評(píng)價(jià)樣品中是否受到糞便的污染。
2、大腸菌群計(jì)數(shù)的高低,直接反映了樣品受糞便污染的程度。
3、表示對(duì)人體健康是否具有潛在的危險(xiǎn)性。大腸菌群是理想的糞便污染的指標(biāo)菌。
4、是人類和溫血?jiǎng)游锬c道菌群,在數(shù)量上占優(yōu)勢(shì)。
5、隨糞便排出體外后,在外界環(huán)境影響下,其存活時(shí)間應(yīng)與腸道致病菌大致相似或稍長(zhǎng)。
6、檢驗(yàn)方法簡(jiǎn)便,易于檢出與計(jì)數(shù)。
7、對(duì)消毒劑的抵抗力應(yīng)不低于腸道致病菌。
四、大腸菌群在不同培養(yǎng)基上的形態(tài):
1、大場(chǎng)菌群在LST培養(yǎng)基里陽(yáng)性結(jié)果

2、大場(chǎng)菌群在BGLB培養(yǎng)基里陽(yáng)性結(jié)果

3、大場(chǎng)菌群在結(jié)晶紫中性紅膽鹽瓊脂VRBA上的菌落特征
4、大場(chǎng)菌群在去氧膽酸鈉鹽瓊脂上的菌落特征

5、大場(chǎng)菌群在伊紅美藍(lán)瓊脂上的菌落特征

6、大場(chǎng)菌群在顯色培養(yǎng)基上的菌落特征

五、大腸菌群檢驗(yàn)MPN法接種量剖析:
接種量問題,GB 4789.3 -2016中 7.2 初發(fā)酵試驗(yàn)規(guī)定“選擇3個(gè)適宜的連續(xù)稀釋度的樣品勻液,每個(gè)稀釋度接種3管LST肉湯,每管接種1mL(如超過1mL,則用雙料LST)”。這里所說的接種量1mL并非1mL樣品接種量(即MPN檢索表中的1mL樣品接種量),而是接種的稀釋液的體積V=1mL(為了區(qū)分,本文中用V表示),那么實(shí)際的接種量m(為了區(qū)分,本文中用m來表示)為m×p(p為稀釋液濃度)。那么括號(hào)中的接種量超過1mL就是要V>1mL,而MPN檢索表中的實(shí)際接種量都為10-n系列數(shù),所以V也只可能是10mL(100mL在實(shí)際中不可能),也就是說接種體積V=1mL,用單料,V=10mL用雙料。
例如:25g樣品+225mL緩沖液—1:10稀釋液
1:10稀釋液+9mL緩沖液—1:100稀釋液
若:1:10稀釋液接種10mL至雙料LST,接種量為:10mL×0.1g/mL=1g
1:10稀釋液接種1 mL至單料LST,接種量為:1mL×0.1g/mL=0.1g
1:100稀釋液接種1 mL至單料LST,接種量為:1mL×0.1g/mL=0.01g
培養(yǎng)基裝量在GB 4789.3-2016中沒有作任何說明,所以各人的理解更是不一,可能有的人單雙料都用10mL,有的人用9mL,有的更多或更少。那么到底培養(yǎng)基裝量有沒有什么規(guī)則,是不是怎樣都行?
其實(shí)不是,GB/T 5750.12—2006中總大腸菌群檢測(cè)方法中2.1.5.1.1中使用的是單料雙料都是10mL,這實(shí)際上是為了使得接種稀釋液后所有的發(fā)酵管培養(yǎng)基濃度達(dá)到培養(yǎng)基本身的使用濃度。雙料10mL,再接種10mL稀釋液后濃度降低一倍就還原了培養(yǎng)基本身的使用濃度,而單料它本身就是培養(yǎng)基的使用濃度,那么接種1mL稀釋液后為了使培養(yǎng)基的濃度不至降低太多,就要讓培養(yǎng)基裝量盡可能的多,但是試管的裝量也是有限度的,所以選擇裝量在10mL左右比較合適。
五、大腸菌群檢驗(yàn)MPN法注意事項(xiàng)及要點(diǎn):
1、MPN法注意事項(xiàng):
•全過程不得超過15min。
•樣品勻液的pH值應(yīng)在6.5~7.5之間,
•(如接種量需要超過1mL,則用雙料LST肉湯)
•以48h±2h為最終觀察結(jié)果時(shí)限。結(jié)果也以此時(shí)為最終結(jié)果。
2、MPN法培養(yǎng)基:LST、BGLB:
(1)月桂基磺酸鹽胰蛋白胨(LST)
月桂基磺酸鈉能抑制革蘭氏陽(yáng)性菌的生長(zhǎng),同時(shí)比膽鹽的選擇性和穩(wěn)定性好。由于膽鹽與酸產(chǎn)生沉淀,沉淀有時(shí)候會(huì)使對(duì)產(chǎn)氣情況的觀察變得有些困難;
•乳糖是大腸菌群可利用發(fā)酵的糖類。有利于大腸菌群的生長(zhǎng)繁殖并有助于鑒別大腸菌群和腸道致病菌;
•胰蛋白胨提供基本的營(yíng)養(yǎng)成分;
•LST肉湯是國(guó)際上通用的培養(yǎng)基,與乳糖膽鹽肉湯的作用和意義相同,但具有更多的優(yōu)越性。
•發(fā)酵試驗(yàn)判定原則:產(chǎn)氣為陽(yáng)性。
•檢測(cè)步驟減少(不必分離培養(yǎng)),檢測(cè)時(shí)間縮短24h。
•注:如接種量超過1mL,則應(yīng)用雙料LST肉湯
(2)煌綠乳糖膽鹽肉湯(BGLB)
膽鹽可抑制革蘭氏陽(yáng)性菌。
•煌綠是抑菌抗腐劑,可增強(qiáng)對(duì)革蘭氏陽(yáng)性菌的抑制作用。
•乳糖是大腸菌群可利用發(fā)酵的糖類。有利于大腸菌群的生長(zhǎng)繁殖并有助于鑒別大腸菌群和腸道致病菌。
•發(fā)酵試驗(yàn)判定原則:產(chǎn)氣為陽(yáng)性。由于配方里有膽鹽,膽鹽遇到大腸菌群分解。
•乳糖所產(chǎn)生的酸形成膽酸沉淀,培養(yǎng)基可由原來的綠色變?yōu)辄S色,同時(shí)可看到管底通常有沉淀。
3、MPN檢索表的應(yīng)用:
MPN(最可能數(shù)most probable number)是表示樣品中活菌密度的估測(cè)。因此MPN值只是活菌密度的估算值,并不是樣品中活菌數(shù)的真值。
4、使用MPN檢索表的注意點(diǎn):
•這個(gè)MPN檢索表是ISO、FDA、AOAC、USDA/FSIS、北歐等標(biāo)準(zhǔn)通用的。
•表里的數(shù)字是有小數(shù)點(diǎn)的。
•報(bào)告單位不同。現(xiàn)報(bào)告單位為g/ml,而原報(bào)告單位是100g/ml。
•原標(biāo)準(zhǔn)MPN表有64個(gè)組合,而現(xiàn)標(biāo)準(zhǔn)MPN表只有40個(gè)組合。
當(dāng)實(shí)驗(yàn)結(jié)果在MPN表中無法查找到MPN值時(shí),如:陽(yáng)性管數(shù)為122,123,232,233等時(shí),建議增加稀釋度(可做4~5個(gè)稀釋度),使樣品的最高稀釋度能達(dá)到獲得陰性終點(diǎn)(如果污染程度不能判定,則多加一稀釋度),然后再遵循相關(guān)的規(guī)則進(jìn)行查找,最終確定MPN值。








當(dāng)前所在頁(yè)面:















